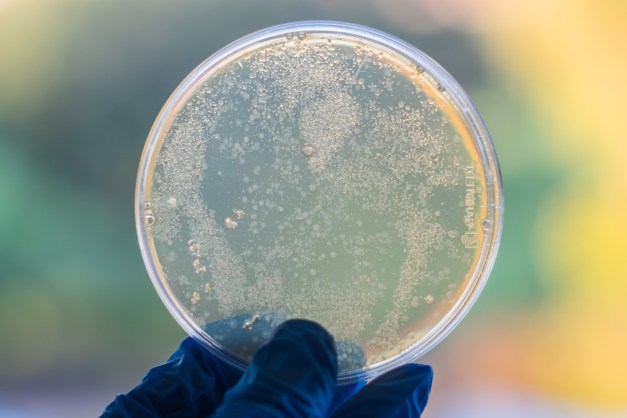
DSCF2809 - The Molecular Factory.jpg

by Abi Sofyan Ghifari
Science communication is increasingly needed these days. It is a wonderful tool to showcase what scientists do, translate knowledge from the laboratory bench to real-life applications, and narrow down distance between academia and society. Moreover, by communicating a scientific study and the research that supports it to the lay audience, we may reduce misunderstandings and pseudo-scientific rumours.
Earlier this year, I had a chance to showcase my skills in doing some science communication using photographs as media. The annual photography competition was held by the ARC Centre of Excellence in Plant Energy Biology, a research centre in The University of Western Australia, Perth Australia, where I do my research on plant mitochondrial biochemistry and plant biology. The competition was simple. All we need to do is to upload images showcasing related scientific activities, objects, or persons with a caption intended for avid readers. The idea is to showcase the science we do in the centre and how it might relate to everyday life and hopefully inspire people about the knowledge. With the ever-increasing social media rise, this is a perfect way for a scientist to reach a wider audience and enhance their research impact.
I have enjoyed photography for a while, mainly since I arrived in Perth to begin my studies. I was lucky enough that the judges (which consist of internal science communicators and Western Australian media practitioners) chose two of my submitted images as prize winners. Having been involved in this event, I have picked some experiences and lessons learned in science communication, especially with photography as a tool.
- A great content tells stories
Whatever your medium is, whether it is a scientific article, a blog post, or a popular article, a great content is always the one that tells a story. The same principle also goes for photography, especially as a picture tells a thousand words. There should be some meaningful insights behind the objects, however insignificant they might seem. In my case for this photography competition, the image needed to be strong in terms of content and techniques which allows them to be understandable and relatable to the audience. Captions can be used to tell further stories and might show the hidden stories behind the picture.
- Simpler is often better
While I agree that there is no perfect formula or secret recipe to tell stories in a better way, I tend to enjoy stories with simple approaches and humble yet engaging language. However, it is pretty hard to apply this principle in science. We, people who work in academia, tend to use a “hard science” approach, especially if we had written research proposals, articles, and numerous assessments throughout our study. This approach often makes our work full of jargon and terms, ordered in a perfect structure with references. We often forget that we don’t need to use the same approach if we want our work to be understood by people in other areas of expertise or to the wider society.
- Be honest
I think this is the most important lesson I learned from the competition. As scientists, we tend to over-glow our scientific results and achievements while deteriorate any failed procedures or negative results. The truth is science has a lot of failures behind even the smallest success, and it’s good to embrace this failure. It’s better to communicate these failures to the public rather than sugar-coat them because the public are entitled to know processes behind a good science practice. Communicating failures can also be beneficial for others to help with identifying problems and come up with solutions.
Behind every successful study, there are many laborious works that require thorough attentions. This agar plate grows Escherichia coli, a bacterial species widely used to produce biological molecules, mainly recombinant DNA and protein.
- Visibility and accessibility
Communicating science through pictures is not a new idea. Printed media such as newspaper and magazines like National Geographic already demonstrated the power of photography to convey messages related to the importance of science. However, with the massively increasing use of social media such as Twitter and Instagram, pictures become more powerful as a tool to communicate science. Uploading science photos to a social media platform is a good strategy to rapidly increase the visibility and accessibility of the research, which are often hidden behind paywalled journals that are inaccessible to the public. Science photos also improve public engagement. This can be seen as a lot of laboratories and research centres have joined various social media platforms to showcase their research and spark public attention and discussion. See some of my science I have captured in photos.
Science communication will always be needed to bridge and transfer knowledge from scientists to the wider society. With the increasing use of social media, photographs become a powerful tool of delivering ideas in an instant, which may trigger public discussion that benefit both scientists and the society.
About Me:
I am a PhD student in School of Molecular Sciences and ARC Centre of Excellence in Plant Energy Biology, The University of Western Australia, where I study plant mitochondrial biochemistry and molecular biology. Currently, I am doing a lipidomics research as an intern at the RIKEN Center for Integrative Medical Sciences (IMS), Yokohama, Japan. When not in the lab doing science, I enjoy reading fictions and casually strolling around doing some photography. You can find me on Twitter/Instagram @abighifari or my blog Ghifari’s Notebook (http://abighifari.wordpress.com). If you’d like to know more of my work, please don’t hesitate to get in touch.


Reblogged this on Ghifari's Notebook and commented:
My science communication article has been published in The Biochemist Blog (owned by The Biochemical Society, UK). This article tells the story of my experience in competing a scientific photography competition and what did I learn from this.
LikeLike
Reblogged this on Photo Search and commented:
science, science communication, scientific method, scientific communication,
LikeLike